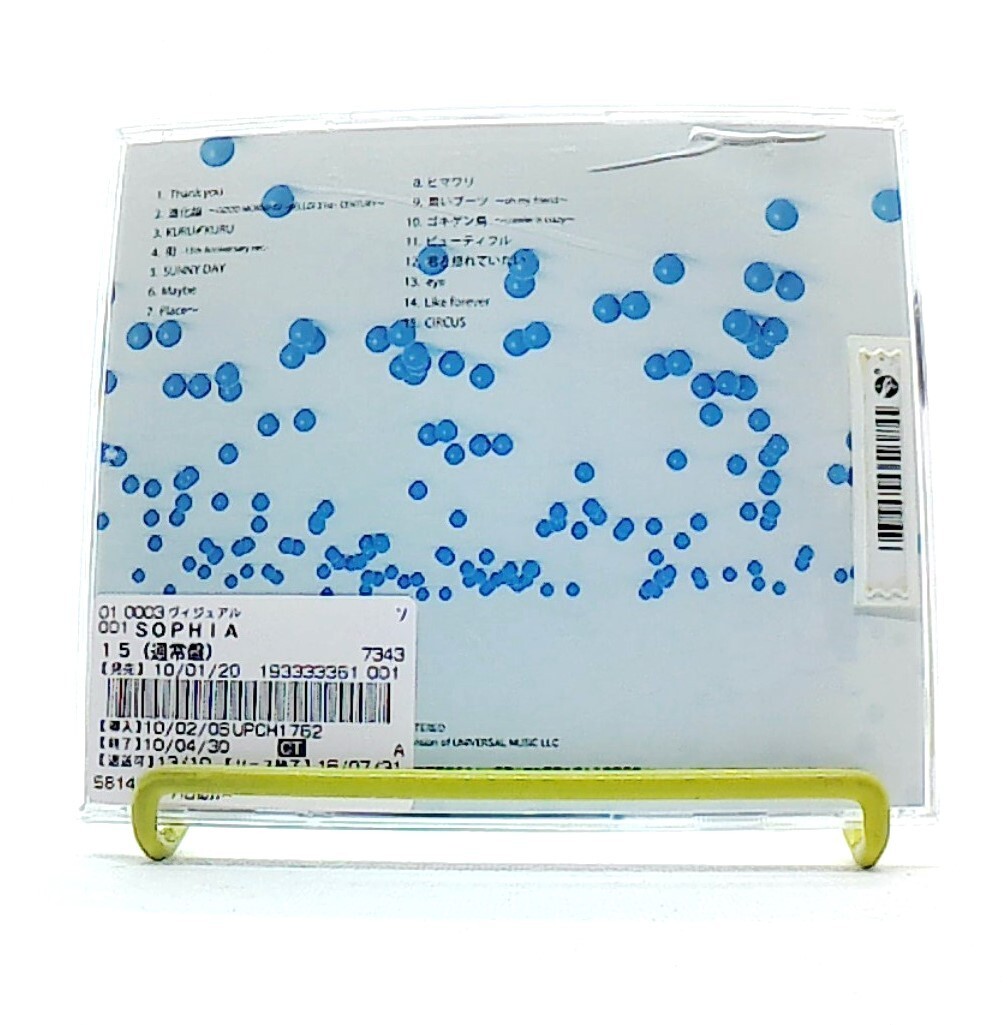

マイストア
変更
お店で受け取る
(送料無料)
配送する
納期目安:
2025.09.27 20:56頃のお届け予定です。
決済方法が、クレジット、代金引換の場合に限ります。その他の決済方法の場合はこちらをご確認ください。
※土・日・祝日の注文の場合や在庫状況によって、商品のお届けにお時間をいただく場合がございます。
SOPHIA CD アートワーク付き SOPHIA CD アートワーク付き SOPHIA CD アートワーク付き | 邦楽の詳細情報
SOPHIA CD アートワーク付き SOPHIA CD アートワーク付き | 邦楽。SOPHIA CD アートワーク付き SOPHIA CD アートワーク付き | 邦楽。SOPHIA CD ジャケット 写真集 - メルカリ。SOPHIAのCD、青空デザインのアートワーク付き。確か限定のCDだったと思います。拡大して頂くとわかるとおもいますが、パッケージの状態はそこまでキレイではないです。ただ、中の歌詞カードはそんなに見ていなかったのか、キレイだと思います。もしよろしければお願い致します┏○ペコッ- アーティスト名: SOPHIA- CDのタイトル: SOPHIA- パッケージデザイン: アートワークは青空と雲のデザイン- 収録内容: 収録曲の詳細は不明だが、邦楽であることが示唆されている- 特典: カードなどの付属品あり- 状態: 目立った傷や汚れは見当たらないご覧いただきありがとうございます。。2025年最新】SOPHIA CDの人気アイテム - メルカリ。Silver Rose / ~Dear Argent~ 終止符。ZARD Best Request通常版+特典詞ブロック 揺れる想い 完売品。レトリバー様 XG MILLION PLACES 新品未開封 22枚。QURULI Q.M.V. くるり完全生産限定BOX・グッズ(未開封新品)
ベストセラーランキングです
近くの売り場の商品
カスタマーレビュー
オススメ度 4.5点
現在、4385件のレビューが投稿されています。